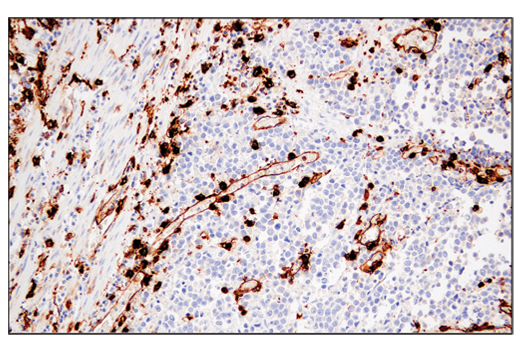
undefined Image 31: Late-Onset Alzheimer's Disease Risk Gene Antibody Sampler Kit
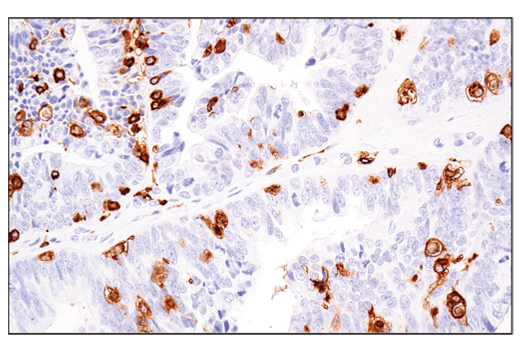
undefined Image 46: Late-Onset Alzheimer's Disease Risk Gene Antibody Sampler Kit

Revision 3
#36833
Store at -20C
Late-Onset Alzheimer's Disease Risk Gene Antibody Sampler Kit
1 Kit
(9 x 20 microliters)
877-616-CELL (2355)
877-678-TECH (8324)
3 Trask Lane | Danvers | Massachusetts | 01923 | USA
For Research Use Only. Not for Use in Diagnostic Procedures.
| Product Includes | Product # | Quantity | Mol. Wt | Isotype/Source |
|---|---|---|---|---|
| BIN1 (E4A1P) Rabbit Monoclonal Antibody | 51844 | 20 µl | 45-80 kDa | Rabbit IgG |
| SORL1 (D8D4G) Rabbit Monoclonal Antibody | 79322 | 20 µl | 250 kDa | Rabbit IgG |
| TREM2 (D8I4C) Rabbit Monoclonal Antibody | 91068 | 20 µl | 28 kDa | Rabbit IgG |
| ApoE (pan) (D7I9N) Rabbit Monoclonal Antibody | 13366 | 20 µl | 35 kDa | Rabbit IgG |
| Clusterin (D7N2K) Rabbit Monoclonal Antibody | 34642 | 20 µl | 35-42, 65, 75 kDa | Rabbit IgG |
| ApoE4 (E5M4L) Rabbit Monoclonal Antibody | 39327 | 20 µl | 35 kDa | Rabbit IgG |
| EphA1 (D6V7I) Rabbit Monoclonal Antibody | 90673 | 20 µl | 130 kDa | Rabbit IgG |
| MEF2C (D80C1) Rabbit Monoclonal Antibody | 5030 | 20 µl | 50-60 kDa | Rabbit IgG |
| MHC Class II (LGII-612.14) Mouse Monoclonal Antibody | 68258 | 20 µl | 25-35, 50-65 kDa | Mouse IgG1 |
| Anti-rabbit IgG, HRP-linked Antibody | 7074 | 100 µl | Goat |
Please visit cellsignal.com for individual component applications, species cross-reactivity, dilutions, protocols, and additional product information.
Description
Storage
Background
APOE has three allele variants: ApoE2, ApoE3, and ApoE4. ApoE4 is associated with an increased risk of AD. Evidence suggests that this risk occurs through promotion of amyloid-beta plaque aggregation (1). ApoE4 is also associated with impaired microglial response, lipid transport, synaptic integrity and plasticity, glucose metabolism, and cerebrovascular integrity (4). Mutations in BIN1, primarily involved in endocytosis and maintaining cytoskeletal integrity in the brain, are suggested to play a role in the aggravation of tau pathology (5,6). Increased levels of BIN1 have been seen in AD postmortem brain tissue (6). SORL1 expression is decreased in the brain of AD patients (7). Studies have demonstrated a role for SORL1 as a neuronal sorting receptor that binds amyloid precursor protein (APP) and regulates its trafficking and proteolytic processing, thus regulating β-amyloid (Aβ) peptide production (8). The triggering receptor expressed on myeloid cells 2 (TREM2) is an innate immune receptor that is expressed on the cell surface of microglia, macrophages, osteoclasts, and immature dendritic cells (9). Research studies using AD mouse models indicate that deficiency and haploinsufficiency of TREM2 can lead to increased Aβ accumulation due to dysfunctional microglia response (10). EphA1 is a member of the ephrin family of receptor tyrosine kinases responsible for regulating cell morphology and motility (11). In the central nervous system (CNS), EphA1 plays a role in synaptic plasticity and axon guidance (12). EphA1 is involved in inflammatory signaling pathways (13), which may mean it plays a role in regulation of neuroinflammatory processes in AD (14). MEF2C is a member of the myocyte enhancer factor 2 (MEF2) family of transcription factors shown to play a role in learning and memory formation through regulation of synaptic plasticity (15). Studies have shown that MEF2C may play a role in age-related microglial activation through IFN-I associated MEF2C deregulation (16,17). MEF2C may also act as a modulator for APP proteolytic processing of Aβ (18,19). Clusterin (CLU) is a multifunctional glycoprotein shown to play a protective role in AD by sequestering Aβ40 peptides to form long-lived, stable complexes, which prevent amyloid fibril formation (20-22). Major histocompatibility complex class II (MHC class II) molecules are transmembrane glycoproteins expressed on the surface of antigen-presenting cells that bind exogenous peptide antigens derived from endocytosed extracellular proteins digested in the lysosome (23,24). Increases in MHC class II-expressing microglia have been shown in AD brain (25).
Background References
- Selkoe, D.J. (2001) Physiol Rev 81, 741-66.
- Jansen, I.E. et al. (2019) Nat Genet 51, 404-413.
- Zhang, Q. et al. (2020) Nat Commun 11, 4799.
- Yamazaki, Y. et al. (2019) Nat Rev Neurol 15, 501-518.
- Franzmeier, N. et al. (2019) Nat Commun 10, 1766.
- Chapuis, J. et al. (2013) Mol Psychiatry 18, 1225-34.
- Scherzer, C.R. et al. (2004) Arch Neurol 61, 1200-5.
- Andersen, O.M. et al. (2005) Proc Natl Acad Sci U S A 102, 13461-6.
- Colonna, M. (2003) Nat Rev Immunol 3, 445-53.
- Wang, Y. et al. (2015) Cell 160, 1061-71.
- Yamazaki, T. et al. (2009) J Cell Sci 122, 243-55.
- Lai, K.O. and Ip, N.Y. (2009) Curr Opin Neurobiol 19, 275-83.
- Ivanov, A.I. and Romanovsky, A.A. (2006) IUBMB Life 58, 389-94.
- Villegas-Llerena, C. et al. (2016) Curr Opin Neurobiol 36, 74-81.
- Rashid, A.J. et al. (2014) Genes Brain Behav 13, 118-25.
- Xue, F. et al. (2021) Neurobiol Dis 152, 105272.
- Deczkowska, A. et al. (2017) Nat Commun 8, 717.
- Tang, S.S. et al. (2016) Oncotarget 7, 39136-39142.
- Camargo, L.M. et al. (2015) PLoS One 10, e0115369.
- Yerbury, J.J. et al. (2007) FASEB J 21, 2312-22.
- Narayan, P. et al. (2011) Nat Struct Mol Biol 19, 79-83.
- Desikan, R.S. et al. (2014) JAMA Neurol 71, 180-7.
- Ting, J.P. and Trowsdale, J. (2002) Cell 109 Suppl, S21-33.
- Cresswell, P. (1994) Annu Rev Immunol 12, 259-93.
- Perlmutter, L.S. et al. (1992) J Neurosci Res 33, 549-58.
Trademarks and Patents
Cell Signaling Technology is a trademark of Cell Signaling Technology, Inc.
All other trademarks are the property of their respective owners. Visit cellsignal.com/trademarks for more information.
Limited Uses
Except as otherwise expressly agreed in a writing signed by a legally authorized representative of CST, the following terms apply to Products provided by CST, its affiliates or its distributors. Any Customer's terms and conditions that are in addition to, or different from, those contained herein, unless separately accepted in writing by a legally authorized representative of CST, are rejected and are of no force or effect.
Products are labeled with For Research Use Only or a similar labeling statement and have not been approved, cleared, or licensed by the FDA or other regulatory foreign or domestic entity, for any purpose. Customer shall not use any Product for any diagnostic or therapeutic purpose, or otherwise in any manner that conflicts with its labeling statement. Products sold or licensed by CST are provided for Customer as the end-user and solely for research and development uses. Any use of Product for diagnostic, prophylactic or therapeutic purposes, or any purchase of Product for resale (alone or as a component) or other commercial purpose, requires a separate license from CST. Customer shall (a) not sell, license, loan, donate or otherwise transfer or make available any Product to any third party, whether alone or in combination with other materials, or use the Products to manufacture any commercial products, (b) not copy, modify, reverse engineer, decompile, disassemble or otherwise attempt to discover the underlying structure or technology of the Products, or use the Products for the purpose of developing any products or services that would compete with CST products or services, (c) not alter or remove from the Products any trademarks, trade names, logos, patent or copyright notices or markings, (d) use the Products solely in accordance with CST Product Terms of Sale and any applicable documentation, and (e) comply with any license, terms of service or similar agreement with respect to any third party products or services used by Customer in connection with the Products.
Revision 3



Revision 3



Revision 3



Revision 3



Revision 3



Revision 3



Revision 3



Revision 3



Revision 3



Revision 3



Revision 3

Revision 3



Revision 3



Revision 3



Revision 3



Revision 3

Revision 3



Revision 3
Simple Western™ analysis of lysates (0.1 mg/mL) from 293T cells transfected with constructs expressing full-length human ApoE4 protein using ApoE4 (E5M4L) Rabbit mAb #39327. The virtual lane view (left) shows the target band (as indicated) at 1:10 and 1:50 dilutions of primary antibody. The corresponding electropherogram view (right) plots chemiluminescence by molecular weight along the capillary at 1:10 (blue line) and 1:50 (green line) dilutions of primary antibody. This experiment was performed under reducing conditions on the Jess™ Simple Western instrument from ProteinSimple, a BioTechne brand, using the 2-40 kDa separation module.



Revision 3
